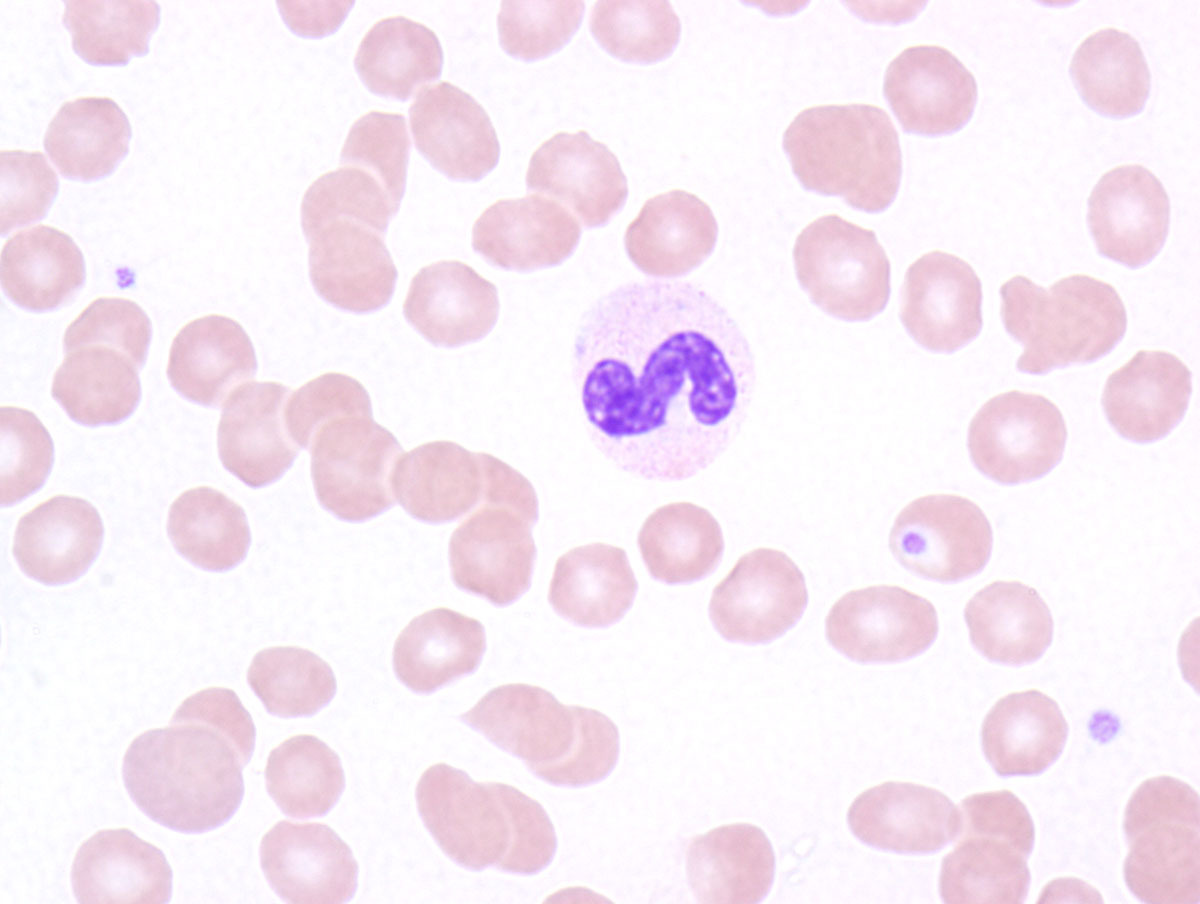
Peripheral blood with hypolobated neutrophils

Institution: Stanford University
Additional authors:Robert Ohgami, MD, PhD
Session: AML with recurrent genetic mutations Part II
HISTORY
62-year-old woman who presented with neutropenia and decreasing platelets. The patient was treated with standard 7+3 (Cytarabine and Idarubicin) with consolidation with cytarabine. She achieved clinical remission but experienced morphologic recurrence after 18 months from her initial diagnosis and therapy and thereafter continued to experience relapses until after her third relapse she entered into hospice care 41 months from her initial diagnosis.
DETAILS
A bone marrow aspirate and biopsy were performed. The bone marrow underwent rapid decalcification and Bouin’s fixation.
The CBC findings were as follows:
WBC: 1.6 K/uL; RBC: 3.65 MIL/uL; HGB: 11.0 g/dL; HCT: 31.0%; MCV: 85.1 fL; RDW: 12.8%; PLT: 188 K/uL; MANUAL DIFF: SEG NEU: 7%; BAND NEU: 10%; METAMYELOCYTES: 1%; LYM: 71%; MONO: 3%; EOS: 1%; BLASTS 7%.
The blood showed circulating blasts with associated hypogranular neutrophils and moderate anisocytosis. The marrow showed an increase in blasts (38%) with dysplastic erythroid precursors and atypical megakaryocytes.
IMMUNOHISTOCHEMISTRY AND FLOW CYTOMETRY
Flow cytometry immunophenotyping showed blasts that expressed CD33, CD117 and myeloperoxidase with dim partial expression of CD64 and weak CD79A. The blasts were negative for CD13, CD34, HLA-DR and all other lymphoid antigens.
CYTOGENETIC FINDINGS
Cytogenetics studies showed a normal female karyotype
MOLECULAR FINDINGS
Molecular genetic studies detected an NPM1 mutation without FLT3 ITD, D835 or CEBPA mutations and hypermethylation of GSTM1.
INTERESTING FEATURES
This case highlights the controversy around the diagnosis of AML with myelodysplasia-related changes based solely on the detection of multilineage dysplasia, especially in the setting of an NPM1 mutation. AML with mutated NPM1, in the absence of a FLT3 mutation, is considered to have an improved prognosis, but we have previously demonstrated that methylation of GSTM1 is associated with a poor prognosis. While multilineage dysplasia alone is associated with a poor prognosis in our studies, others have found it to lack significance. While NPM1 mutations, in the absence of FLT3 mutations, are associated with a favorable prognosis, NPM1 mutations, as demonstrated by this case, often do not occur in isolation. Complex genetic factors commonly occur in AML patients, even with a normal karyotype, and the classification of leukemias based on a single factor can be problematic.
PROPOSED DIAGNOSIS
Acute myeloid leukemia with myelodysplasia-related changes (multilineage dysplasia) with a normal karyotype, NPM1 mutation and hypermethylation of GSTM1.
CONSENSUS GROUP: ADDITIONAL INFORMATION/STUDIES
Additional immunostains performed by consensus group:
NPM1: Cytoplasmic positivity in some areas of the biopsy
CONSENSUS DIAGNOSIS
Acute myeloid leukemia with NPM1 mutation and hypermethylation of GSTM1
| Peripheral blood with hypolobated neutrophils | |
| Marrow aspirate with hyperlobated megakaryocytes, hypogranular neutrophils and blasts |  |
| Bone marrow aspirate with blasts and erythroid dyspoiesis |  |
| Bone marrow aspirate with blasts and erythroid dyspoiesis |  |
| Bone marrow aspirate with blasts and a markedly dysplastic erythroid precursor |  |
| Bone marrow trephine biopsy with increased mononuclear cells and some small megakaryocytes with pyknotic nuclei |  |
| Bone marrow trephine biopsy with aggregates of immature cells, consistent with blasts |  |